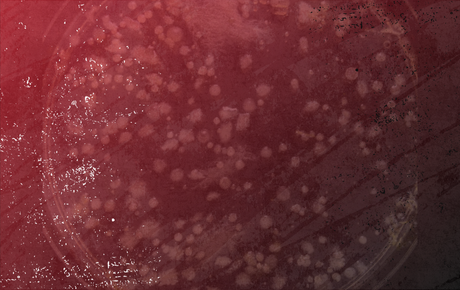
Background

Shows
Locally Produced Shows on WHYR
Hosted by Madison Square
ALTitude
ALTitude is a live radio show filled with melodic alternative music spanning the 70s-today. It can be very British and is always very good. Big players: Elvis Costello, Squeeze, XTC, They Might Be Giants, Billy Bragg, David Bowie, Jellyfish…+ a Beatle Break to pay tribute to the Fab Four. You’ll hear classic alt songs AND learn new ones you’ll rush to add to your library.
Schedule
The Ambient Door
The Ambient Door features progressive ambient electronic music from all around the world.
Schedule
Hosted by DJ Ally Bea
The BEAtle Juice Show
You’ll hear everything from Lil Wayne to Kaytranada. And DJ Ally Bea will get you caught up on pop culture’s most interesting stories!
Schedule
Hosted by Captain Christopher
The Clearing
Capt. Christopher hosts and produces a 2 hour programme of meditative, contemplative, & soft styles of music every Saturday evening. The show is an eclectic mix of new age, soft folk, jazz, light classical, & ethnic. Selections of spiritual, electronic, & ambient are also heard.
Schedule
Hosted by Robert Sherman
Down the Road
Down the Road celebrates the music and musicians from New Orleans and the surrounding areas. We play Traditional Jazz, Swing, Funk, Klezmer, Rock, Rhythm and Blues, Brass Band, Ragtime, Soul, and stuff that defies categorization. From Louis Armstrong to the Rebirth Brass Band, from Sidney Bechet to the Panorama Jazz Band, from Dave Bartholomew to the Tin Men, you will hear the best sounds from the Crescent City.
Schedule
Hosted by Baton Rouge Group of the Sierra Club
Environmental Update
Environmental Update is a weekly look at local environmental issues – and the local aspects of state, national, and global issues.
Schedule
Hosted by KP
The Front Porch
Round out your humpday with The Front Porch, a solid hour of your favorite alt-country and Americana tunes. The Front Porch features the likes of Jason Isbell, Robert Earl Keen, Lucero, Reckless Kelly, and some other great stuff that probably won’t compete for the CMAs (but we like it that way!). From time to time we’ll even throw in some of the old guard, like Willie, Waylon & the boys.
Schedule
Hosted by Dr. Jazz
Gifts and Messages
One of the most authoritative voices in jazz programming in the US returns to the airwaves on Saturday afternoons with Gifts and Messages. Dr. Jazz began his broadcasting adventures in Boston on WNEU/WRBB at Northeastern University in 1967. He has hosted programs in Ithaca, NY and Charlottesville, VA before arriving in Baton Rouge, where he was long-time jazz program/music director at KLSU until 1995. After an extended stint as a scientific journal editor, Dr. Jazz once again brings his fire and dedication to the music for serious jazz aficionados in the Capital City. Gifts & Messages is one of only 12 jazz radio shows featured (and accessible 24/7) world-wide on allaboutjazz.com the premier site for jazz on the web.
Schedule
Hosted by Dr. Charles Lee, LSU School of Veterinary Medicine
The Groks Science Show
The Groks Science Show is a weekly science radio program. Each week, the host, Dr. Charles Lee, takes an in-depth look at recent events in the world of science and technology. Each episode features an interview with a leading scientist, researcher, or industrialist discussing stimulating work in their field. Tune in each week and rediscover the world as you think you know it.
Schedule
Hosted by Zulu Doc and Sunrise Sam
High Cotton Radio
High Cotton Radio is your home for the traditional country, blues, gospel and folk music that was recorded prior to the year 1975. We call this “gutbucket music”, symbolizing the homemade instruments which used to be played by the pioneers of traditional early American music. Much of the popular Americana, Rock and Roll, and R &B music which followed 1975 was inspired by the music we feature…we believe this music is the “guts” of the American sound.
Schedule
Hosted by Dr. K
It’s For Folks
High Cotton Radio is your home for the traditional country, blues, gospel and folk music that was recorded prior to the year 1975. We call this “gutbucket music”, symbolizing the homemade instruments which used to be played by the pioneers of traditional early American music. Much of the popular Americana, Rock and Roll, and R &B music which followed 1975 was inspired by the music we feature…we believe this music is the “guts” of the American sound.
Schedule
Hosted by JT and Whitney
Life is a Rock
Looking at history through the eyes of rock, Life is a Rock looks at a week in rock history. This show features old rock & roll, classic rock, blues, soul and more—playing songs that made history and songs about history. History gives us insight into who we were, who we are, and who we’re likely to become. Music, especially music that corresponds to that same history, can give great insight into our deepest emotions as we go through all the events that have shaped our lives. Life is a Rock, looks at our history through the eyes of rock/roll – the music that expressed our lives, our times, and even our future.
Schedule
Hosted by Coach Perry Daniels, Eric Hatfield, and Lyndell Mitchell
Louisiana All-American Sports Show
Louisiana All American Sports delivers high school, college, and professional sports coverage. What sets this show apart from other sports talk shows is its commitment to addressing social issues, be it within the world of sports or not. They provide a unique commentary on local, national and global issues. They have in depth interviews with high school and college coaches, administrators, current and former players, as well as community leaders. The LAAS Friday night game-of-the-week airs Fridays during high school football and basketball season starting at 7:00 p.m.; the weekly two-hour show is every Saturday year-round starting at 10:00 a.m.
Schedule
Hosted by Cindy Wonderful
Locals Only
Locals Only is a half hour exploration of the music from the residents of Baton Rouge hosted by Cindy Wonderful. All genres. All local.
Schedule
Hosted by Matt Bruce and Marcel P. Black
The Low Down
This one-hour underground hip-hop and rap show featuring local and national artists aired on Community Radio some years ago and now returns weekly with co-hosts Matt Bruce and Marcel P. Black.
Schedule
Hosted by Uncle Bob
Music Lagniappe
Music Lagniappe is home of today’s modern adult rock and pop music. You’ll hear artists like Adele, Arcade Fire, The Black Keyes, along with up & coming singer-songwriters. In the mix are classic rock & pop legends like U2, Eric Clapton, Fleetwood Mac, flavored with home-grown Louisiana artists like Mark Broussard, Benjy Davis Project, and the Neville Brothers.
Schedule

Hosted by Noel Jackson
Noel Jackson Music Satisfaction
Music Satisfaction is a classics and oldies show with an emphasis on Southern soul music and R&B. Join Noel Jackson as he pulls from multiple troves of recordings, designing his setlist as he goes.
Schedule
Hosted by Leah Smith
Off the Record
Off the Record highlights a variety of music, ranging from blues to rock from the 1940’s to today with a focus on 1960’s vinyl.
Schedule
One World! Your World!
Schedule
Hosted by DJ Diamond Don
Parallel Planet
Parallel Planet is a carefully curated hour-long wave of music, meant to de-stress and de-clutter your Thursday afternoon. It’s a place where the finest new releases can segue into floaty instrumentals, bookended with brief psychedelia and classic rock n’ roll charm. plant a freak flag with us on the Parallel Planet.
Schedule
Hosted by Jared Hromadka
Poiesis
“Production,” “creation,” “making,” each of these is a translation for the Greek root from which our English word “poetry” derives. The Greek word designates the force that flows through a work of art into the mind that perceives it. Poiesis seeks out such acts of becoming in unfamiliar places as well as in places where the words and forms seem already to belong to us.
Schedule
Hosted by Da Blenda
Sub-85 Reggae
DaBlenda DJz excursions into early reggae music. Sub-85 Reggae focuses on Artist, Style, or Label. All tracks vinyl 45’s, 1985 or earlier.
Schedule
Hosted by Syntheclectico
Syntheclectico
Syntheclectico explores electronic and experimental music, cutting across the boundaries of nations, cultures and genres, including pure electronic works, unique experimental pieces, and music by performers who incorporate electronica with acoustic instruments.
Schedule
Hosted by David Brown
Third Place
There’s home, there’s work and then there’s a third place. Third Place (3dP) is a show featuring local voices and discussions of community issues that typically go unheard on the airwaves in BR. Tune in and get to know the people in your community who are doing just that. Listen in and hear why this city is where it’s @ – full of incredible people, food, music, art, nature, and stories.
Schedule
Hosted by Moose Harris
Urban Flosarus
Anthony Bernard Daniels aka Moose Harris is the host of Urban Flosarus. Originally from New Iberia, Louisiana and studying Jazz & Classical Performance at the University of New Orleans, Daniels spent over a decade in the Music Business as a Singer, Songwriter, Lyricist, Musician, Producer, and Business Man, before starting Urban Flosarus in August 2010. Under the motto of “Playing Anything with a Groove from Louis Armstrong to The Roots,” Urban Flosarus specializes in playing the best in Independent, Underground, Exclusive Hip-Hop, R&B, and other urban genres from around the world.
Schedule
Syndicated Shows on WHYR
Alternative Radio
Alternative Radio, established in 1986, is an award-winning weekly one-hour public affairs program offered free to all public radio stations in the U.S., Canada, Europe and beyond. AR provides information, analyses and views that are frequently ignored or distorted in corporate media. With headquarters based in Boulder, Colorado and with only two full-time and two part-time paid staff, AR airs on over 200 radio stations.
Learn More
Arts Express
Arts Express is a vibrant anthology mix of cultural news, views and interviews, and the organic and intricate ways that art always intertwines and fuses dynamically with political currents of the day. Arts Express provides weekly, in-depth coverage of film; arts news and scoops with a hard core political edge; art alerts and Best Of The Net Hotspots for listeners; and contemplative voyages through web culture served up with an enticing, multi-cultural international flavor.
Learn More
Arab Voices
Arab Voices is an award-winning independent radio talk show that presents special programs and distinguished guests, covering a wide range of issues such as the Arab world, its history, culture and civilization, Arab-Americans, civil rights and liberties, immigration issues, media coverage of events about the Arab world, the U.S. Foreign Policy towards the Middle East, and much more. Arab Voices debunks many of the stereotypes, myths and false information disseminated by certain media outlets, some politicians and others.
Learn More
Between the Lines
Between The Lines is a weekly syndicated half-hour radio newsmagazine featuring progressive perspectives on national and international political, economic and social issues. Because Between The Lines is independent of all publications, media networks or political parties, it is able to bring a diversity of voices to the airwaves. This award-winning program provides a platform for individuals and organizations generally ignored or marginalized in corporate media. Each week, Between The Lines features a five-minute summary of some of the week’s under-reported news stories gathered from the alternative press and other sources and three in-depth interview segments focusing on significant international, national and regional issues.
Learn More
Counter Spin
Counter Spin is a production of FAIR, the national media watch group, which has been offering well-documented criticism of media bias and censorship since 1986. FAIR works to invigorate the First Amendment by advocating for greater diversity in the press and by scrutinizing media practices that marginalize public interest, minority and dissenting viewpoints. As an anti-censorship organization, FAIR exposes neglected news stories and defends working journalists when they are muzzled. As a progressive group, FAIR believes that structural reform is ultimately needed to break up the dominant media conglomerates, establish independent public broadcasting, and promote strong non-profit sources of information.
Learn More
Democracy Now!
Democracy Now! produces a daily, global, independent news hour hosted by award-winning journalists Amy Goodman and Juan González. Its reporting includes breaking daily news headlines and in-depth interviews with people on the front lines of the world’s most pressing issues. On Democracy Now!, you’ll hear a diversity of voices speaking for themselves, providing a unique and sometimes provocative perspective on global events.
Learn More
For the Wild
For the Wild is a one-hour weekly syndicated show that describes itself “an anthology of the Anthropocene” and addresses issues like decolonization, ecological restoration, and social and environmental justice.
Learn More
Keeping Democracy Alive
Keeping Democracy Alive with Burt Cohen is a bi-weekly podcast that tackles a wide range of today’s social, economic, and political issues. eeping This show informs and entertains, with lively invigorating conversations that help explain where we are, how we got here, and most important: what we can do to keep our frail democracy alive, making it stronger for the better future we deserve.
Learn More
Law and Disorder
Law and Disorder is a weekly, independent civil liberties radio program airing on more than 100 stations across the United States. Law and Disorder provides timely legal perspectives on issues concerning civil liberties, privacy, right to dissent and practices of torture exercised by the US government and private corporations. Guests are leading authorities in their fields from around the country, and sometimes internationally.
Learn More
Le Show
Part-time New Orleans resident Harry Shearer hosts a look at the worlds of media, politics, cyberspace, sports and show business while providing an eclectic array of music along the way.
Learn More
Making Contact
Founded in 1994, International Media Project is an independent, non-profit organization committed to investigative journalism, in-depth critical analysis, the promotion of civic participation and the dissemination of educational material. Its core focus is Making Contact.
Learn More
National Native News
National Native News provides listeners with relevant, timely coverage of Native American and Indigenous communities. National Native News is a headline news service that provides a Native perspective.
Learn More
The Ralph Nader Radio Hour
The Ralph Nader Radio Hour is a weekly talk show. Ralph Nader is joined by co-hosts Steve Skrovan and David Feldman for a lively informative hour of interviews with some of the nation’s most influential movers and shakers, and thought provoking discussions of the weeks news.
Learn More
The Scenario Radio Show
The Scenario is a syndicated radio show, created to provide a forum for the ‘original Hip-Hop generation’. show we provide music, interviews, and discussion on a wide range of topics, including politics, entertainment, relationships, and the variety of social issues that captivate our attention, from day to day.
Learn More
Sea Change Radio
Sea Change Radio is a weekly show covering the shifts to social, environmental, and economic sustainability. Sea Change Radio is nationally syndicated and podcast globally.
Learn More
Spoiler Alert Radio
Spoiler Alert Radio is conversations on the craft of filmmaking. Each week, host Toni Pennacchia provides a retrospective look at independent artists in filmmaking: directors, cinematographers, composers, writers, and animators from across the globe.
Learn More
Sprouts
Sprouts: Radio From the Grassroots is a radio program that celebrates community stories. Coordinated by Pacifica Radio’s Affiliate Network, Sprouts showcases audio production at community radio stations and independent production groups from around the world. It is renowned for its diverse local voices, brought to a global media platform.
Learn More
This Way Out
This Way Out is the only internationally distributed weekly LGBTQ radio program, currently airing on some 200 local community radio stations around the world. The award-winning half-hour magazine-style program features a summary of some of the major news events in or affecting the queer community, in-depth coverage of major events, interviews with key queer figures, plus music, literature, entertainment — all the information and culture of a community on the move!
Learn More
WINGS
Women’s International News Gathering Service is an all-woman independent radio production company that produces and distributes news and current affairs programs by and about women around the world. WINGS programs can be heard on local radio stations, on shortwave, on the internet, and on cassettes.
Learn More